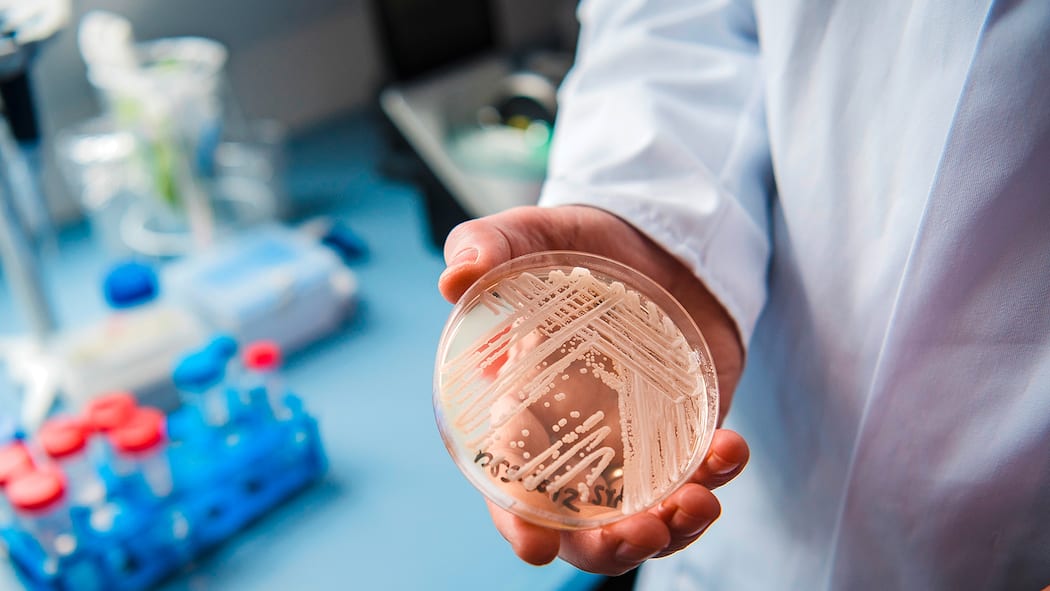
Dieser Pilz tötet Petrischale mit dem resistenten Hefepilz Candida auris.

«Die meisten Spitalinfektionen entstehen durch körpereigene Bakterien»
In vielen europäischen Spitälern breitet sich ein ansteckender Pilz aus. Und was ist mit der Schweiz? Der Beobachter sprach mit dem Infektiologen Philipp Jent vom Inselspital Bern.

Veröffentlicht am 26. September 2025 - 11:26 Uhr

«Der Hefepilz Candidozyma auris ist besonders problematisch, weil er oft gegen gängige Antipilzmittel resistent ist»: Philipp Jent
Der krankheitserregende Pilz Candidozyma auris verbreitet sich rasant in europäischen Spitälern. Das zeigt ein aktueller Bericht des Europäischen Zentrums für die Prävention und die Kontrolle von Krankheiten (ECDC). Die meisten Fälle wurden in Spanien gemeldet, gefolgt von Griechenland, Italien und Rumänien. Auch in der Schweiz gibt es mehrere Fälle.
Der Hefepilz – früher bekannt als Candida auris oder schlicht C. auris – wurde 2009 erstmals in Japan entdeckt. Seither hat er sich weltweit verbreitet, besonders in Kliniken. Der Pilz ist gegen mehrere Medikamente resistent und kann bei Menschen mit geschwächtem Immunsystem schwere Infektionen auslösen.
Der Beobachter sprach mit dem Infektiologen Philipp Jent über diesen Pilz und die Lage in der Schweiz.
Beobachter: Philipp Jent, wie gefährlich ist der resistente Pilz Candidozyma auris, der sich in europäischen Krankenhäusern ausbreitet und auch schon in der Schweiz gemeldet wurde?
Philipp Jent: Candidozyma auris ist besonders problematisch, weil er häufig gegen gängige Antipilzmittel resistent ist und aussergewöhnlich lange auf Oberflächen überlebt. Dadurch kommt es in vielen Ländern zu Ausbrüchen in Spitälern und Pflegeheimen, und der Erreger konnte sich weltweit rasch verbreiten.
Also ist er sehr gefährlich?
Für die meisten Menschen bleibt eine Besiedelung folgenlos, Erkrankungen treten nur selten auf. In der Schweiz handelt es sich bislang fast ausschliesslich um importierte Fälle aus dem Ausland. Mit zunehmender Häufigkeit ist es jedoch nur eine Frage der Zeit, bis auch hier Ausbrüche auftreten können.
Zur Person
Wer ist besonders gefährdet?
Gefährdet sind vor allem Patientinnen und Patienten, deren natürliche Mikroflora durch Antibiotika- oder Antimykotika-Therapien geschwächt ist, sowie Personen mit vielen Implantaten oder Gefässkathetern.
«Besiedelte Personen werden konsequent isoliert.»
Was machen die Spitäler dagegen?
Wir haben die weltweite Entwicklung früh beobachtet und bereits vor über fünf Jahren begonnen, Risikopatienten aus dem Ausland gezielt zu testen und nötigenfalls zu isolieren. Besiedelte Personen werden konsequent isoliert, und umfassende Hygienemassnahmen verhindern eine Weiterverbreitung. An der Insel-Gruppe konnten wir bereits über 220 Patiententage mit dem Hefepilz Candidozyma auris betreuen – ohne eine einzige Übertragung. Ein sorgfältiger Einsatz von Antibiotika trägt zusätzlich dazu bei, das Risiko einer Ausbreitung zu reduzieren.
Welche anderen Infektionskeime sind gefährlich?
Besonders im Fokus stehen multiresistente Bakterien, vor allem sogenannte Carbapenemase-Bildner. Sie sind resistent gegen wichtige Reserveantibiotika und werden ebenfalls häufig aus dem Ausland eingeschleppt. Schweizer Spitäler konnten Ausbrüche bislang jeweils rasch eindämmen – mit Isolation, Contact-Tracing, intensiven Reinigungsprotokollen und striktem Antibiotikamanagement.
«Spitalinfektionen lassen sich nie ganz vermeiden.»
Laut dem Bundesamt für Gesundheit erleiden rund sechs Prozent aller Patientinnen und Patienten in Schweizer Spitälern während ihres Aufenthalts eine Infektion. Am häufigsten sind Wundinfektionen nach Operationen sowie Blutvergiftungen.
Spitalinfektionen lassen sich nie ganz vermeiden, da medizinische Eingriffe oft natürliche Schutzbarrieren wie die Haut durchbrechen. Auch Katheter, Beatmungsschläuche oder andere notwendige Installationen erhöhen das Risiko. Gleichzeitig investieren Spitäler viel in Präventionsmassnahmen, die das Risiko deutlich senken können.
Wie schützen sich Patientinnen und Patienten am besten davor?
Die meisten Spitalinfektionen entstehen durch körpereigene Bakterien. Patientinnen und Patienten können vor allem zu ihrem Schutz beitragen, indem sie an empfohlenen Präventionsprogrammen teilnehmen und gemeinsam mit den behandelnden Ärztinnen und Ärzten auf einen sorgfältigen Einsatz von Antibiotika achten.
Seit Jahren wird vor Spitalinfektionen gewarnt: Muss man tatsächlich Angst haben?
Ein gewisses Grundrisiko bleibt, da Operationen und Katheter immer ein Einfallstor für Infektionen darstellen. Die Spitäler sind jedoch in den letzten Jahren deutlich besser geworden, Präventionsmassnahmen gezielt einzusetzen. So konnte die Infektionsrate trotz älterer Patientinnen und Patienten und steigender Eingriffszahlen stabil gehalten werden.
- European Centre for Disease Prevention and Control (ECDC): Drug-resistant fungus Candidozyma auris confirmed to spread rapidly in European hospitals: ECDC calls for urgent action
- Bundesamt für Gesundheit: Strategie NOSO: Spital- und Pflegeheiminfektionen reduzieren
- «Tages-Anzeiger»: Spital-Pilz breitet sich weiter aus – mehrere Fälle in der Schweiz gemeldet